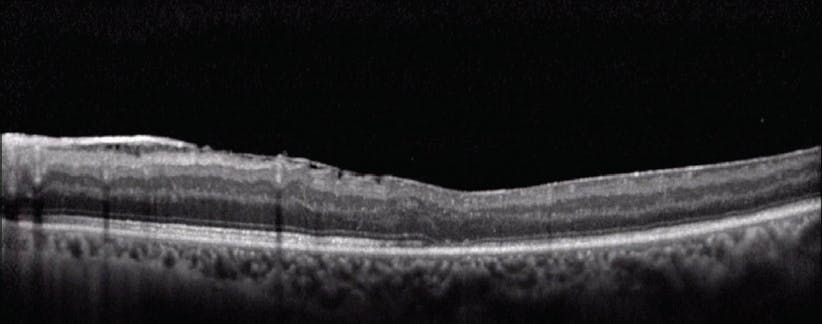

Sympathetic ophthalmia (SO) is a rare bilateral granulomatous panuveitis believed to be an autoimmune response following injury to one eye.1-3 The precedent ocular insult may be either accidental or surgical: The incidence of SO has been estimated to be between 0.2% and 1% following penetrating ocular injury and at 0.01% following intraocular surgery.4 The time to disease onset varies widely, but approximately 80% of patients are diagnosed within the first 3 months following injury.4,5 Patients commonly present with blurred vision in the sympathizing eye and may also experience pain, floaters, epiphora, or photophobia.3,6 Granulomatous or nongranulomatous inflammation of the anterior segment may develop;3 in the early stage, however, SO may present only in the posterior segment.7 In fluorescein angiography, multiple or diffuse leakage sites at the level of the retinal pigment epithelium are commonly observed, and staining of the optic nerve head is sometimes seen.3,5,7,8 OCT can reveal retinal edema, if present, and may be used to monitor therapeutic progress.2 While rare, SO is sight-threatening and requires early and aggressive treatment.5,9 In one retrospective study of 32 SO patients seen at the National Eye Institute Uveitis Clinic, 10 patients (31%) had an outcome VA of 20/200 or worse.9 This case study describes a patient with blindness-threatening SO. Being unable to tolerate systemic corticosteroid therapy and not being a candidate for immunomodulatory therapy, the patient was treated with RETISERT (fluocinolone acetonide intravitreal implant) 0.59 mg therapy for control of chronic inflammation involving the posterior uveal segment.
Case Report: Sympathetic Ophthalmia
BACKGROUND: A 53-year-old man with a history of chronic obstructive pulmonary disease (COPD) experienced a globe rupture in his right eye, which ultimately required enucleation. The patient subsequently developed inflammation in the left eye, which was suggestive of SO. To manage flares of panuveitis, the patient had been treated intermittently with oral prednisone but did not return for regular follow-ups because of his medical comorbidities.
DIAGNOSIS: The patient’s left eye had a VA of 20/400 and an IOP of 29 mm Hg. Wide-field fundus photography demonstrated optic nerve cupping (Figure 1A). Extensive glaucomatous damage was evident through glaucoma hemifield testing (Figure 1B) and OCT analysis of the retinal nerve fiber layer (Figure 1C). The patient was diagnosed with advanced primary open-angle glaucoma (POAG).

Figure 1. Evidence of glaucoma. Wide-field fundus photograph (A) showed cupping of the optic nerve. The finding of a glaucoma hemifield test (B) was outside normal limits. OCT analysis, as seen in quadrant and sector thickness charts (C), demonstrated thinning of the retinal nerve fiber layer.
Fluorescein angiography of the left eye revealed diffuse leakage along the retinal capillaries and enhancement of the left optic nerve, consistent with active SO (Figure 2).3,5,7,8 OCT of the left eye demonstrated macular puckering with no retinal edema (Figure 3). The patient underwent a number of laboratory tests, including rapid plasma reagin, interferon gamma release assay, and fluorescent treponemal antibody absorption, all of which yielded results negative for syphilis or tuberculosis, thus reducing the possibility for the associated infectious uveitides.10 Results from an enzyme-linked immunosorbent assay for antibodies against Borrelia burgdorferi were also negative, which reduced the possibility of infectious uveitis due to Lyme disease.10 Additionally, the patient tested negative for antibodies against Bartonella henselae, which reduced the possibility of inflammation arising from cat-scratch disease.11 Based on the findings from these tests and the history of globe rupture in the right eye, the patient was diagnosed with SO.

Figure 2. Fundus fluorescein angiogram. Staining showed diffuse capillary leakage and optic nerve enhancement.
TREATMENT: To manage IOP elevation, the patient was given brimonidine tartrate, 0.2%, administered three times a day, as well as dorzolamide-timolol (dorzolamide hydrochloride, 2%, and timolol maleate, 0.5%), administered twice a day. For the inflammation, the patient received prednisone for use up to 80 mg per day. However, the patient would only follow-up when he experienced a flare of inflammation. While maintaining use of prednisone, he developed pneumonia and required hospitalization multiple times, which led to more missed clinic follow-ups.
WHY RETISERT? The patient was unable to tolerate the dose of prednisone. He was also not a candidate for immunomodulatory therapy because of his frequent hospitalizations from lung infections and his inability to attend follow-up visits. With a VA at 20/400, he was at risk of going blind. The patient needed a therapy that offered long-term control of inflammation.12 RETISERT is a viable alternative therapy for patients who are intolerant to systemic therapies such as prednisone.12
RETISERT is designed to release fluocinolone acetonide locally over approximately 2.5 years.13 Although RETISERT can provide long-term control, it is associated with adverse events, including IOP elevation and cataract formation.13 Thus, RETISERT implantation in a patient with glaucoma should be approached with caution. The patient had POAG and was unable to tolerate prednisone therapy, and I recommended that he receive a glaucoma drainage valve and RETISERT implant simultaneously in his left eye (Figure 4).

Figure 4. Simultaneous implantation of glaucoma drainage valve and RETISERT. The glaucoma drainage valve was implanted first, as seen in placement of the valve plate (A). The RETISERT implant was then prepared by suturing through the hole in the anchoring strut (B). The RETISERT implant was inserted approximately 4 mm posterior to the limbus (C), and the scleral incision was closed (D). Finally, an optional scleral graft was placed over the RETISERT wound (E).
FOLLOW-UP: In the immediate weeks after the surgery, the patient experienced a temporary decrease in visual acuity. The patient was tapered off prednisone therapy shortly after the procedure. In a follow-up approximately 3 months following the surgery, the patient had a VA of 20/60 and an IOP of 5 mm Hg. He was no longer receiving prednisone therapy or IOP-lowering ophthalmic solutions. The patient did not experience any flares of uveitic inflammation following the procedure. He also did not experience any adverse events related to cataract or IOP elevation over the 3 months following RETISERT implantation. Unfortunately, he passed away after the 3-month follow-up due to complications from pneumonia.
Conclusions
This case study describes a patient diagnosed with SO, a rare, sight-threatening bilateral granulomatous panuveitis that manifests in the sympathizing eye following injury to the fellow eye.1,5,7 The patient’s injured eye was enucleated, but this did not prevent the onset of SO. COPD that developed into recurring pneumonia and led to multiple hospitalizations prevented successful treatment with prednisone and precluded candidacy for immunomodulatory therapy. The patient had a history of uveitic flares, had developed POAG, and was at risk of going blind. He received a RETISERT implant to treat the posterior segment inflammation caused by SO, along with a glaucoma drainage valve to control glaucomatous progression. The patient was tapered off of prednisone and at his 3-month follow-up had not experienced any flares of uveitic inflammation.
Indication
RETISERT® (fluocinolone acetonide intravitreal implant) 0.59 mg is a corticosteroid indicated for the treatment of chronic noninfectious uveitis affecting the posterior segment of the eye.
Important Safety Information
- Surgical placement of RETISERT® (fluocinolone acetonide intravitreal implant) 0.59 mg is contraindicated in active viral, bacterial, mycobacterial or fungal infections of the eye.
- Based on clinical trials with RETISERT®, during the 3‐year post‐implantation period, nearly all phakic eyes are expected to develop cataracts and require cataract surgery.
- As with any surgical procedure, there is risk involved. Potential complications accompanying intraocular surgery to place RETISERT® into the vitreous cavity may include, but are not limited to, the following: cataract formation, choroidal detachment, endophthalmitis, hypotony, increased intraocular pressure, exacerbation of intraocular inflammation, retinal detachment, vitreous hemorrhage, vitreous loss, and wound dehiscence.
- Following implantation of RETISERT®, nearly all patients will experience an immediate and temporary decrease in visual acuity in the implanted eye which lasts for approximately one to four weeks post‐operatively.
- Use of corticosteroids may result in elevated IOP and/or glaucoma. Based on clinical trials with RETISERT®, within 3 years post‐implantation, approximately 77% of patients will require IOP lowering medications to control intraocular pressure and 37% of patients will require filtering procedures to control intraocular pressure.
- Patients should be advised to have ophthalmologic follow‐up examinations of both eyes at appropriate intervals following implantation of RETISERT®. Physicians should periodically monitor the integrity of the implant by visual inspection.
- Ocular administration of corticosteroids has been associated with delayed wound healing and perforation of the globe where there is thinning of the sclera.
- The most frequently reported ocular adverse events in clinical trials with RETISERT® occurring in 50‐90% of patients included: cataract, increased intraocular pressure, procedural complications and eye pain. The most common non‐ocular event reported was headache (33%).
Click here for full Prescribing Information for RETISERT®.


RETISERT and the RETISERT READY logo are trademarks of Bausch & Lomb Incorporated or its affiliates.
© 2023 Bausch & Lomb Incorporated or its affiliates. All rights reserved. RET.0053.USA.20_v3
1. Damico FM, Kiss S, Young LH. Sympathetic ophthalmia. Semin Ophthalmol. 2005;20(3):191-197.
2. Chu XK, Chan CC. Sympathetic ophthalmia: to the twenty-first century and beyond. J Ophthalmic Inflamm Infect. 2013;3(1):49.
3. Arevalo JF, Garcia RA, Al-Dhibi HA, Sanchez JG, Suarez-Tata L. Update on sympathetic ophthalmia. Middle East Afr J Ophthalmol. 2012;19(1):13-21.
4. Marak GE Jr. Recent advances in sympathetic ophthalmia. Surv Ophthalmol. 1979;24(3):141-156.
5. Rao NA, Marak GE Jr. Sympathetic uveitis. In: Yanoff M, Duker JS, eds. Ophthalmology. 3rd ed. Saint Louis, MO: Mosby Elsevier; 2009:861-863.
6. Tan XL, Seen S, Dutta Majumder P, et al. Analysis of 130 cases of sympathetic ophthalmia: a retrospective multicenter case series. Ocul Immunol Inflamm. 2019;27(8):1259-1266.
7. Gupta V, Gupta A, Dogra MR. Posterior sympathetic ophthalmia: a single centre long-term study of 40 patients from North India. Eye (Lond). 2008;22(12):1459-1464.
8. Ozbek Z, Arikan G, Yaman A, Oner H, Bajin MS, Saatci AO. Sympathetic ophthalmia following vitreoretinal surgery. Int Ophthalmol. 2010;30(2):221-227.
9. Chan CC, Roberge RG, Whitcup SM, Nussenblatt RB. 32 cases of sympathetic ophthalmia: a retrospective study at the National Eye Institute, Bethesda, Md., from 1982 to 1992. Arch Ophthalmol. 1995;113(5):597-600.
10. Lin P. Infectious uveitis. Curr Ophthalmol Rep. 2015;3(3):170-183.
11. Preciado Gómez VM, Palestine A, Shantha J, et al. Cat scratch disease. EyeWiki website. https://eyewiki.aao.org/Cat_scratch_disease. Updated April 17, 2020. Accessed August 7, 2020.
12. RETISERT [prescribing information]. Bausch & Lomb Incorporated.
13. Haghjou N, Soheilian M, Abdekhodaie MJ. Sustained release intraocular drug delivery devices for treatment of uveitis. J Ophthalmic Vis Res. 2011;6(4):317-329.